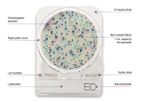
Compact Dry™ - Microbial Testing Kit

- Home
- Companies
Refine by
Industries served
- Monitoring and Testing
- Environmental
- Agriculture
- Water and Wastewater
- Soil and Groundwater
- Health and Safety
- Chemical & Pharmaceuticals
- Air and Climate
- Energy
- Manufacturing, Other
- Food and Beverage
- Construction & Construction Materials
- Waste and Recycling
- University / Academia / Research
- Medical / Health Care
- Oil, Gas & Refineries
- Plastics & Resins
- Textile
- Automobile & Ground Transport
- Aerospace & Air Transport
- Defense
- Packaging
- Government
- Metal
- Paint
- Pulp & Paper
- Mining
- Maritime/Shipbuild/Water Transport
- Electronics and Computers
- Forestry & Wood
- Banking & Finance / Insurance / Legal
- Dry Cleaning
- Domestic
- Glassware
- Retail
- Printing
- Real Estate
Environmental Industry Laboratory
230 companies found

Laboratorybased inDodge City, KANSAS (USA)
Servi-Tech was organized in 1975 by three farmer-owned cooperatives to provide technical service for agricultural producers in southwest Kansas. In 1981, Servi-Tech expanded into northeast Colorado, then into Nebraska in 1983, and finally into Iowa ...
Profitable fertilizer recommendations require accurate soil testing. At Servi-Tech Laboratories, our goal is to help producers raise crops as efficiently and profitably as possible. If one of the packages below doesn’t fit your needs, please call ...

Laboratorybased inChadds Ford, PENNSYLVANIA (USA)
A company should be able to condense its mission statement into a simple phrase. MAC-MOD’s mission statement is “Smarter Chromatography.” But, you may ask, just what does “Smarter Chromatography” mean? It means that when we make a recommendation to ...

Laboratorybased inMt. Laurel, NEW JERSEY (USA)
iATL is an independent environmental laboratory specializing in asbestos testing, lead testing and industrial hygiene testing. iATL is accredited by AIHA, NVLAP and numerous state regulatory agencies. iATL specializes in only two analytes: asbestos ...
iATL also offers testing of Other Metals in air, usually associated with occupational exposures. These include Zinc, Cadmium, and Chromium. AAS lab techniques and NIOSH field protocols are employed. Accreditation is provided through ...
Laboratorybased inKeysborough, AUSTRALIA
SWEP is an independent soil-testing laboratory that works to benefit farmers by increasing productivity and sustainability through balanced soil management. To be sustainable and farm responsibly requires a balanced approach that deals with the ...

Laboratorybased inMumbai, INDIA
The Tansha is a specialized provider of state-of-the-art analytics products and solutions tailored for diverse industries such as healthcare and research. At the core of the company's mission is the delivery of precise, safe, and insightful tools ...
Compact Dry™ is an innovative chromogenic media plate designed for rapid and precise microbial testing. Developed by Nissui Pharmaceuticals Co., Ltd., this ready-to-use plate serves as an efficient alternative to conventional plating methods, ...
Laboratorybased inMt Vernon, MAINE (USA)
Since 1974, scientists dedicated to improving the measure and understanding of agricultural and horticultural environments...We have specialized in testing soils, plants, organic wastes and agrichemicals...Helping to achieve goals of sustainability ...

Laboratorybased inAncaster, ONTARIO (CANADA)
The Actlabs Group of Companies provides contract analytical services covering all aspects of analysis from academic research applications to routine quality control functions. We provide our services to many fields, including Geochemical, ...

Laboratorybased inJacksonville, FLORIDA (USA)
Advanced Environmental Laboratories, Inc. (AEL) is one of the largest and most experienced laboratory networks in Florida. With five NELAP certified labs and across the state providing a broad range of testing, and a management group with well over ...
AEL has experienced field sampling technicians equipped with all the necessary tools to complete most any sampling event. We have technicians who are 40hr HAZWOPER certified and who have completed the Florida DEP Field SOP Training. Experience ...

Laboratorybased inStratford, ONTARIO (CANADA)
Growing from our early beginnings in the 1980’s as a small in-house laboratory that monitored quality control and feedstuff analysis for Daco Laboratories, Stratford Agri Analysis has become a nationally recognized provider of feedstuff analysis. ...
Laboratorybased inKittanning, PENNSYLVANIA (USA)
Originally formed in 1985 as CWM Metiri is a trusted analytical lab delivering environmental testing. You’ll receive timely, dependable results from experts who care about your outcomes as much as you do. has evolved into a diversified full service ...

Laboratorybased inSeattle, WASHINGTON (USA)
The Institute emerged as a result of the new research model called systems biology a revolutionary approach to analyzing biological complexity and understanding how biological systems function. The Institute has brought together a multidisciplinary ...

Laboratorybased inTirgu Mures, ROMANIA
The WESSLING Group guarantees a range of integrated expertise in a sole interlocutor. Our offices are located in 28 different European cities and this provides us a global knowledge of distinctive local laws, aside from the Community regulations, ...
Emissions and immissions are two key words for assessment of presence of harmful airborne substances, phenomena known as air pollution. The measurement of emis-sions and immissions for controlling air pollution is an important factor for our health. ...

Laboratorybased inBerkeley, CALIFORNIA (USA)
C&T labs provides a comprehensive array of environmental analytical services to industrial, engineering/consulting and government clients locally, nationally, and internationally with a staff of 85 chemists and technicians and 45,000 square feet of ...

Laboratorybased inLeominster, MASSACHUSETTS (USA)
Environmental Testing and Research Laboratory has been in the laboratory business since 1995. We are a Central Massachusetts based, full service lab, specializing in the analysis of private drinking water. Our facility has serviced thousands of ...
Our patented, EPA approved, disinfection process, kills and controls microorganisms in your well water. This kit is designed to disinfect shallow and drilled wells effectively, efficiently and safely. The beauty of our product is that you can ...

Laboratorybased inHatfield, PENNSYLVANIA (USA)
Laboratory Testing Inc. is an accredited, independent testing laboratory and calibration company located outside of Philadelphia, PA. Since 1984, customers world-wide have counted on Lab Testing for accurate, affordable materials testing and ...
Quantitative chemical analysis is performed to accurately determine the concentration, amount or percentage of one or more elements in a test sample. This technique, along with qualitative analysis, provides information on what and how much of each ...
Laboratorybased inThane, INDIA
A Modern World Class Laboratory very well equipped with sophisticated instrumentation, complimented by a team of well qualified, dedicated & trained professionals and an experience spanning 27 years has contributed to the core strength & competency ...
Over the years, Envirocare Labs has gained the confidence of its growing clientele, to be their trusted partners in scientific & developmental ...

Laboratorybased inDerby, UNITED KINGDOM
Abbeydale Direct has grown from a small business operating from the family home into a name recognised amongst farmers nationwide. Through listening to farmers Abbeydale Direct has grown, and continues to grow, year on year. With innovative new ...

Laboratorybased inLos Angeles, CALIFORNIA (USA)
Pacific Coast Analytical Services (PCAS) has been providing analytical and consulting services for more than 15 years to the environmental, food and chemical industries. From the first enterprise as a chemical laboratory, PCAS has grown into a state ...
PCAS product development capabilities extend all the way from concept development to commercialization. Our test kitchen offers a wide variety of services under strict confidentiality. PCAS's product developers have more than 20 years in the ...
Laboratorybased inBurlington, WASHINGTON (USA)
Edge Analytical provides a full range of organic, inorganic, and biological analyses of the following: Drinking Water, Wastewater, Soil / Biosolids, Sludge, Food products, Bottled Water, Hydrocarbons. Edge Analytical prides itself in its QA/QC ...
Solid Waste, NPDES - Landfill operators, manufacturers, municipalities - Our up to date knowledge of state regulatory programs will help you stay compliant. At Edge Analytical Laboratories, we analyze industrial and municipal wastewater for ...

Laboratorybased inLakeview, OHIO (USA)
Logan Labs is the leading provider of analytical and consulting services to all areas of the agricultural community. We pride ourselves in quick turnaround time and analytical accuracy. Logan Labs is a participating member of the North America ...